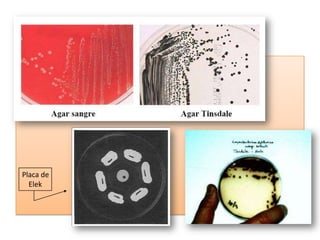
Placa de
Elek

La difteria es una infección aguda causada por Corynebacterium diphtheriae que afecta principalmente las vías respiratorias superiores. Se caracteriza por la formación de membranas que pueden causar daño a órganos como el corazón y los nervios. Fue la primera enfermedad infecciosa controlada mediante la vacunación y el tratamiento oportuno con antitoxina y antibióticos.